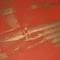

0

Benga
Dubstep musician
1

Skream
Dubstep musician
2

Rusko
English musician
3

Loefah
musical artist
4

DJ Hatcha
British dubstep musician and DJ
5

12th Planet
music producer and DJ
6

Mt Eden
Dubstep and EDM band from New Zealand
7

Seven Lions
American dubstep DJ and producer
8

Caspa
British musician
9

Svdden Death
DJ and producer from San Jose, California
10

Borgore
Israeli DJ and record producer
11

Digital Mystikz
English electronic music duo
12

Cosmic Gate
band
13

Shy FX
record producer
14

Jon Gooch
British DJ
15

Datsik
Canadian DJ, musician, and dubstep producer
16

Route 94
British DJ and producer
17

Plastician
British musician
18

Slushii
American DJ and record producer
19

KOAN Sound
British music production duo
20

Wooli
American music producer
21

Dirtyphonics
French electronic music band
22

Ephixa
Canadian DJ, composer, musician and record producer
23

Markus Schulz
German musician
24

Gammer
British DJ and music producer
25

Au5
American music producer
26

Subtronics
American DJ and producer
27

NGHTMRE
American DJ and producer
28

Adventure Club
Canadian electronic music duo
29

Sharam
Iranian musician
30

Federico Ágreda
Venezuelan composer and music producer
31

Herobust
American record producer and DJ
32

Carnage
Guatemalan singer
33

Kayzo
American DJ and musical artist
34

Fox Stevenson
singer-songwriter and producer of indie electronic dance music
35

Martyn
Dutch dubstep DJ and producer.
36

Zeds Dead
Canadian electronic music duo
37

Tensnake
German DJ
38

Noisia
Dutch electronic music band
39

Lane 8
American musician
40

Flosstradamus
American electronic music project
41

Filo & Peri
American DJs
42

Gary Richards
American music executive
43

Zoe aoki
cantante,actriz y modelo
44

Gareth Emery
English electronic dance music producer and DJ
45

Dash Berlin
Dutch record producer and club dj
46

Deep Dish
duo of DJs and house-music producers
47

Muzzy
British DJ and musical artist
48

Scrufizzer
British musician
49

DJ Sun
American Music Producer and DJ
50

Swedish House Mafia
Swedish Supergroup
51

DJ Umek
Slovenian dance music producer and DJ